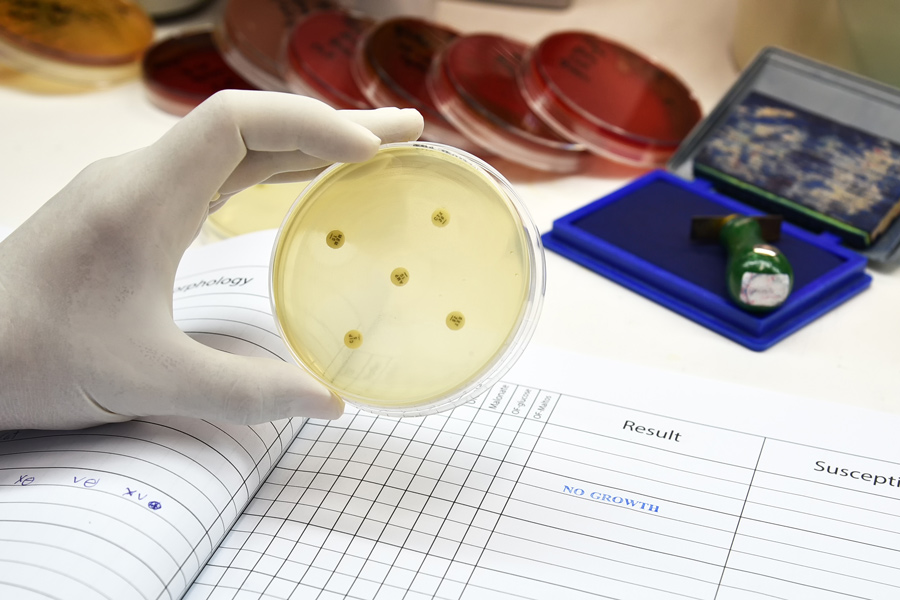

探索家禽垃圾内抗生素基因转移
抗生素抗药性对人类和动物健康构成重大威胁含有抗生素基因的细菌从家禽垃圾中发现,通常从商业鸡生产中发现家禽垃圾常用作土壤肥料,有这种抗生素抗药性移入土壤的危险。美国弗吉尼亚技术大学John Maurer教授显示抗生素抗药性通过实验室内称为粒子的运算器传播然而,当同一种实验在家禽垃圾中展开时,没有看到粒子转移,这表明其他机制可能正在发挥作用。
农业,包括畜牧业需要环境输入,如水提供和饲料生产动物副产品也可以回归环境单在美国,估计家禽养殖场,包括鸡鸡和火鸡,每年产生约2 000万吨肥料大多由家禽垃圾、材料混合、溢出饲料、肥料和羽毛组成,这些都出自家禽生产,然后通过微生物分解
动物肥料,特别是家禽肥料,可有益地补充土壤,因为它增加氮和碳含量,化合物对土壤肥力和作物生长都很重要。禽肥几乎包含所有13种基本植物养分,包括氮、钾和磷特别是氮鼓励绿叶增长家禽肥料常由园中心以干形式售供家庭使用这是因为新鲜家禽垃圾中含有对人类有害的细菌干燥产品制造时常消毒,这意味着如果在家环境使用风险较低
公共卫生考量
John Maurer教授在美国弗吉尼亚理工大学动物科学学院工作研究集中于家禽生产中微生物抗药性生态学、动物和微生物间交互作用(细菌、病毒、真菌)及其对动物健康的影响毛雷尔研究组还致力于更多地了解疾病从动物传播到人的问题,特别是在家禽生产系统内部
maurer解释家禽垃圾含有一亿千兆克细菌许多这些细菌有利于土壤和植物健康,约1-10%的细菌可能用抗生素抗微生物污染土壤。
寄生虫垃圾中还含有可引起疾病的细菌,例如沙门氏菌西里岛或康波克特中可转换成土壤家禽中最著名的致病性(致病性)细菌也许是家禽沙门氏菌近些年来下降的原因是国家控制方案、严格的生物安保措施和鸡群定期测试每一种微生物都要求自己的具体控制措施,因为细菌种类不同。
抗生素抗药性
抗生素抗药性对人类和动物健康构成越来越大的挑战,对全球健康和粮食安全构成重大威胁。抗生素抗药性发生时,细菌不再因现有药而死,使感染更容易处理,因为用抗生素处理抗生素变得不那么有效。疾病控制预防中心估计美国每年抗菌菌菌和真菌近300万例感染
寄生虫垃圾中含有可引起疾病并可转移入土壤的细菌水平抗生素自然发生,随着细菌复制和随机基因变异发生,抗生素使用选择这些变异支配Maurer研究组先前的研究探索农业使用是否有助于抗生素抗药性沙门氏菌鸡中发现发现抗生素处理没有提高水平沙门氏菌抗试也没有向家禽转移抗生素基因库Maurer得出结论说,其他因素对驱动抗生素抗药性负有责任沙门氏菌.
科学家能描述家禽垃圾细菌中发现的抗基因数maurer报告,特定抗生素基因相对常见于家禽垃圾中,并可见于无害和致病细菌中表示抗生素基因可以在家禽垃圾中的细菌间传递方法之一是通过粒子遗传元素打包 并搭载细菌间抗菌基因一般来说,阻抗转移需要细胞对细胞物理接触粒子内抗生素基因常与元素关联,即百分数交换特殊基因并发扬现有抗生素
通过模模传递
maurer和同事调查带抗微生物抗药性金字塔是否可以从一种细菌移到另一种细菌,特别是从抗生素抗药性E.西里岛对抗生素敏感沙门氏菌.
研究者从家禽垃圾中提取细菌 计算抗菌抗四种抗生素家禽垃圾来自两个源头,鸡群保存实验弗吉尼亚技术公司和商业小鸡屋结果表明,细菌生态系统中最高抗药度是对抗生素链片素和四环
研究者假设可能需要特殊条件才能在细菌间转移抗菌性测试多种条件改变细菌生长介质强度、温度和接触时间,细菌细胞试探最优条件,导致家禽垃圾中的细菌间抗生素转移
下一步实验中研究金字塔,结果显示金字塔有可能在不同类型细菌间移动小型脱氧核糖核酸分子对细菌生存很重要,当抗生素出现时尤其如此,因为抗生素允许细菌细胞间传递遗传信息。
等离子体转移抗生素能力因条件设定为98oF(体温)或75oF(家禽屋温度)而异
研究者们还测试 抗生素抗药性交换 是否仍然发生结果表明,即使家禽垃圾中还有其他细菌存在,抗菌抗药性仍然从抗生素抗药性运动E.西里岛对抗生素敏感沙门氏菌受金字塔阻塞
确定条件后,当家禽垃圾细菌出现时,粒子转移量达到最高水平后,小组还探讨是粒子类型还是抗药性细菌菌株影响先前抗生素抗药性结果E.西里岛和抗生素敏感沙门氏菌添加家禽垃圾
然而,当用同一种方法研究家禽垃圾微缩内抗生素转移时(商业家禽垃圾长相的微版),没有观察到抗生素抗药性微交换,尽管使用同样的细菌类型。

研究组想了解含有抗药性基因的低水平某些类型细菌是否是家禽垃圾中未检测到粒子转移的原因并尝试使用另一种比家禽屋温度更适配的金字塔研究结果显示,尽管高抗药性基因通过垃圾中的细菌表达,但似乎没有通过粒子在细菌间传染
其他因素游戏
数组抗生素转移未被观察到可能有几个原因,可能因为家禽垃圾不支持选定实验菌株生长或可能产生干扰粒子丰度或转移因素
垃圾物理性质,如pH或 beding材料类型,也可能起作用,因为其他研究组的研究显示模模转移程度不同。maurer表示未来研究可调查某些类垃圾或家禽管理方法是否更有可能促进家禽垃圾细菌间抗生素基因扩散
即便通过粒子自然转移抗生素,但家禽垃圾或垃圾与土壤之间似乎并不存在这种情况。maurer得出结论说家禽垃圾中的细菌的确含有传播抗生素的粒子然而,尽管本研究所审查条件多种多样,但在标准实验条件下,它们之间传递这些信息的潜力似乎有限。即便通过粒子自然转移抗生素,但家禽垃圾或垃圾与土壤之间似乎并不存在这种情况。
个人响应
是什么启发你展开这项研究我们研究项目的最终目标是识别家禽垃圾孵化条件,如堆肥,这些条件可减少动物粪肥中的抗生素抗药性,防止这种抗生素转移至有害细菌等 沙门氏菌.
家禽垃圾中和垃圾与土壤间转移抗菌药不由粒子组成,
抗生素抗药性转移沙门氏菌鸡类我们相信移位发生在鸡肠沙门氏菌自然居家

